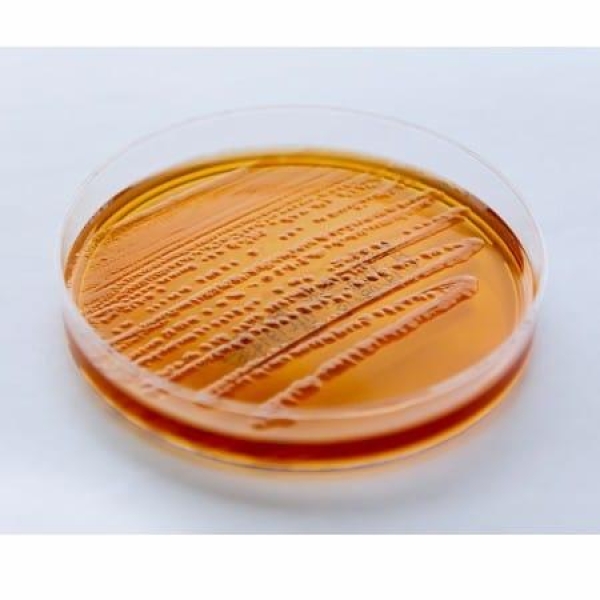
PLACA ÁGAR MAcCONKEY, 90X15mm, PCT COM 10 UNID. - RENYLAB

Nossos Produtos
Conheça nosso portfólio! Oferecemos uma ampla variedade de insumos e equipamentos para laboratórios, garantindo qualidade e inovação para o seu negócio.
PLACA ÁGAR MAcCONKEY, 90X15mm, PCT COM 10 UNID. - RENYLAB
O ágar MacConkey é um meio seletivo, diferencial e de enumeração empregado no isolamento de bactérias gram negativas. Neste meio podem-se diferenciar bactérias fermentadoras da lactose, através da formação de colônias róseas, das bactérias não fermentador